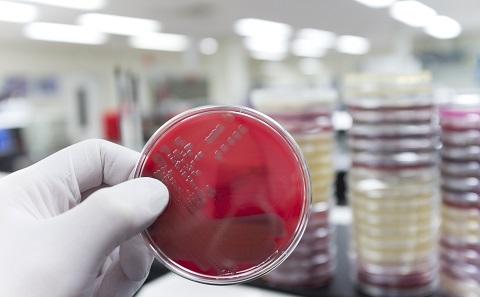
Bug

Urinary Tract Infections
Trial of alternative treatments
It is vital to find out how bacteria develop resistance to antibiotics, to develop new antibiotics through an enhanced understanding of the interactions between cells and bacteria and to improve diagnosis so that exactly the right antibiotic is administered.

Trial of alternative treatments

Used to identify infection in child from Afghanistan

Team conducts feasibility study
.tif_SIA_JPG_fit_to_width_MEDIUM.jpg)
Investigating the response to diffferent strains of NTHi bacteria

Adding Chinese herbal medicine to antibiotic treatment
Using cutting edge sequencing technology in developing countries

Combining research in cell culture and microfluidics

Introducing a new invention, StarHealer, which cleans and stimulates accelerated healing in wounds

Localised use of antibiotics to improve infection management

Understanding which nanoparticles bind to bacteria, in the delivery of antibiotics

A clinical trial evaluating the feasibility of using pelargonium for acute cough

exploring the use of a novel flushing system for cleaning wounds

Targeting bacterial metabolism to reduce antibiotic tolerance

Using simple sugars to clear bacteria and prevent infection

Developing vaccines to combat resistance to antibiotics

A new way of testing antibiotics to help in the fight against TB and other infectious diseases.